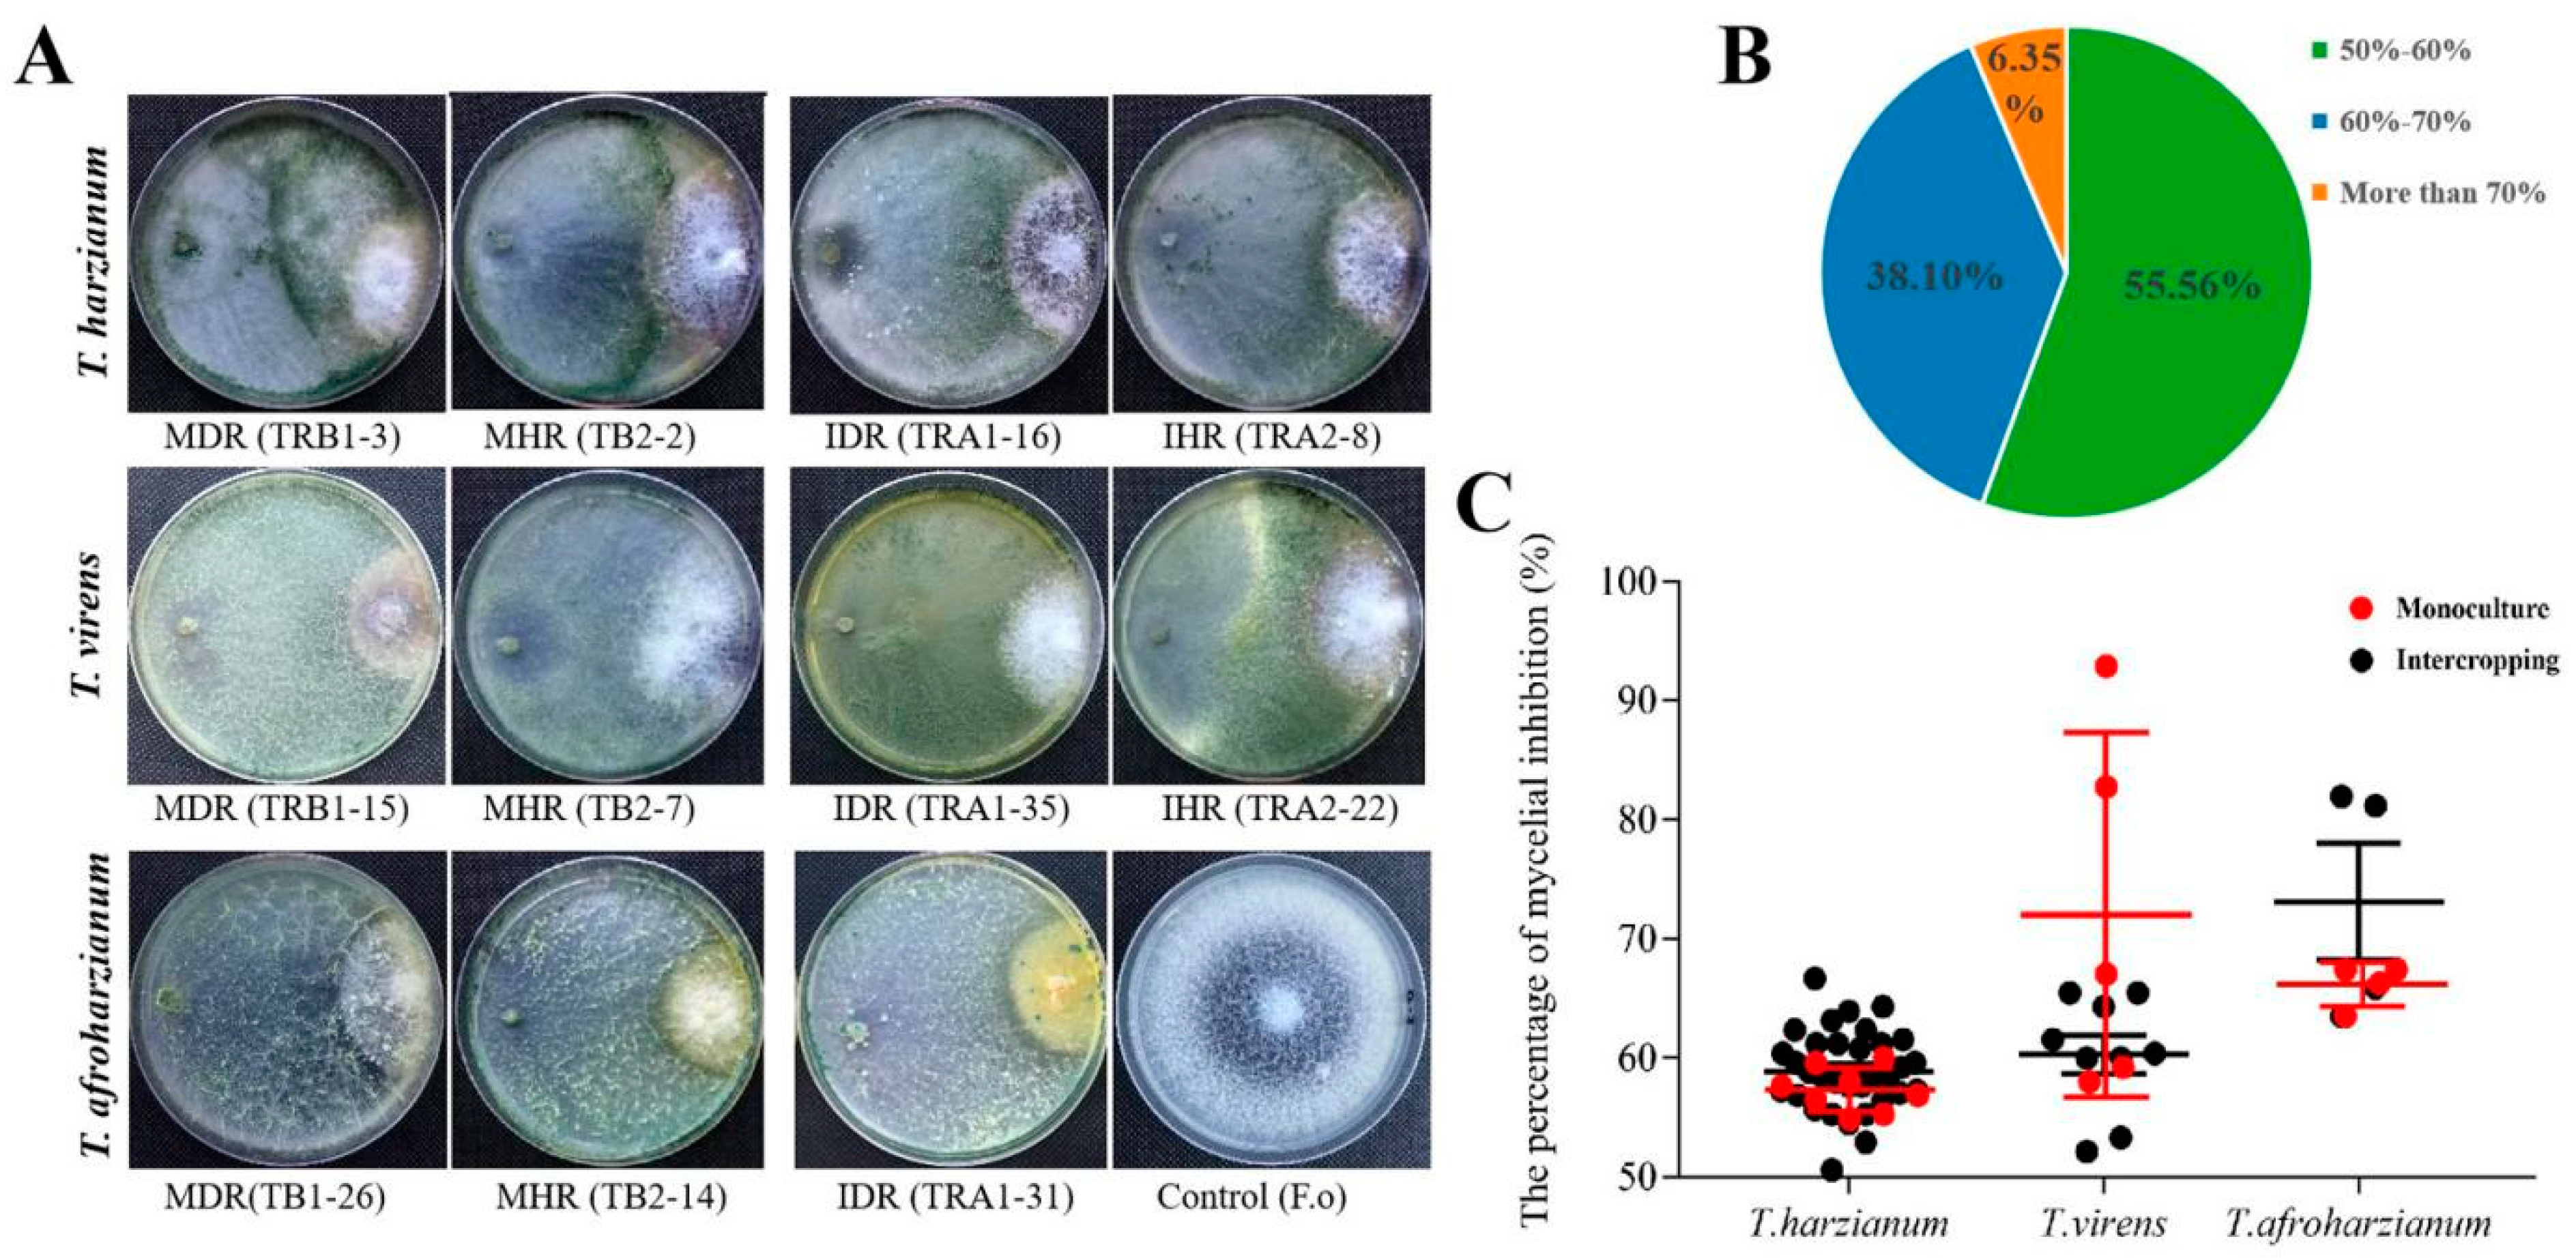
Pathogens 11 00478 g005 550

Changes in the Density and Composition of Rhizosphere Pathogenic Fusarium and Beneficial Trichoderma Contributing to Reduced Root Rot of Intercropped Soybean
Abstract
:1. Introduction
2. Results
2.1. Population Density of Rhizosphere Fusarium and Trichoderma in Response to Intercropping and Monoculture
2.2. Species Identification of Rhizosphere Trichoderma and Fusarium in Response to Intercropping and Monoculture
2.3. Composition and Isolation Proportion of Fusarium spp. and Trichoderma spp. Affected by Intercropping and Monoculture
2.4. The Pathogenicity of Rhizosphere Fusarium spp. on Soybean
2.5. Inhibition Effects of Trichoderma spp. on the Pathogenic F. oxysporum of Soybean Root Rot
3. Discussion
4. Materials and Methods
4.1. Collection of Soil Samples
4.2. Isolation and Purification of Fusarium and Trichoderma
4.3. Richness of Rhizosphere Fusarium and Trichoderma
4.4. DNA Extraction and PCR Amplification
4.5. Phylogenetic Analysis
4.6. Pathogenicity Test of Fusarium Species
4.7. In Vitro Antagonistic Effects of Trichoderma Strains on the Pathogenic F. oxysporum
4.8. Data Analysis
5. Conclusions
Supplementary Materials
Author Contributions
Funding
Acknowledgments
Conflicts of Interest
References
- Díaz-Arias, M.M.; Leandro, L.F.; Munkvold, G.P. Aggressiveness of Fusarium species and impact of root infection on growth and yield of soybeans. Phytopathology 2013, 103, 822–832. [Google Scholar] [CrossRef] [PubMed] [Green Version]
- Hartman, G.L.; Chang, H.X.; Leandro, L.F. Research advances and management of soybean sudden death syndrome. Crop Prot. 2015, 73, 60–66. [Google Scholar] [CrossRef]
- Bandara, A.Y.; Weerasooriya, D.K.; Bradley, C.A.; Allen, T.W.; Esker, P.D. Dissecting the economic impact of soybean diseases in the United States over two decades. PLoS ONE 2015, 15, e0231141. [Google Scholar] [CrossRef] [PubMed] [Green Version]
- Nelson, B.D.; Hansen, J.M.; Windels, C.E.; Helms, T.C. Reaction of soybean cultivars to isolates of Fusarium solani from the Red River Valley. Plant Dis. 1997, 81, 664–668. [Google Scholar] [CrossRef] [PubMed] [Green Version]
- Zhang, J.X.; Xue, A.G.; Cober, E.R.; Morrison, M.J.; Zhang, H.J.; Zhang, S.Z.; Gregorich, E. Prevalence, pathogenicity and cultivar resistance of Fusarium and Rhizoctonia species causing soybean root rot. Can. J. Plant Sci. 2013, 93, 221–236. [Google Scholar] [CrossRef]
- Wei, W.; Xu, Y.L.; Zhu, L.; Zhang, S.L.; Li, S. Impact of long-term continuous cropping on the Fusarium population in soybean rhizosphere. Chin. J. Appl. Ecol. 2014, 25, 497–504. [Google Scholar]
- Chang, X.L.; Yan, L.; Naeem, M.; Khaskheli, M.I.; Zhang, H.; Gong, G.S.; Zhang, M.; Song, C.; Yang, W.Y.; Liu, W.G.; et al. Maize/soybean relay strip intercropping reduces the occurrence of Fusarium root rot and changes the diversity of the pathogenic Fusarium species. Pathogens 2020, 9, 211. [Google Scholar] [CrossRef] [Green Version]
- Chang, X.L.; Dai, H.; Wang, D.P.; Zhou, H.H.; He, W.Q.; Fu, Y.; Ibrahim, F.; Zhou, Y.; Gong, G.S.; Shang, J.; et al. Identification of Fusarium species associated with soybean root rot in Sichuan Province. Eur. J. Plant Pathol. 2018, 151, 563–577. [Google Scholar] [CrossRef]
- Gao, X.; Wu, M.; Xu, R.; Wang, X.; Pan, R.; Kim, H.J.; Liao, H. Root interactions in a maize/soybean intercropping system control soybean soil-borne disease, red crown rot. PLoS ONE 2014, 9, e95031. [Google Scholar] [CrossRef] [Green Version]
- Akamatsu, H.; Kato, M.; Ochi, S.; Mimuro, G.; Matsuoka, J.; Takahashi, M. Variation in the resistance of Japanese soybean cultivars to Phytophthora root and stem rot during the early plant growth stages and the effects of a fungicide seed treatment. Plant Pathol. J. 2019, 35, 219–233. [Google Scholar] [CrossRef]
- Sepiol, C.J.; Yu, J.; Dhaubhadel, S. Genome-wide identification of chalroot specific GmCHRs and Phytophthora sojae cone reductase gene family in soybean: Insight into resistance. Front. Plant Sci. 2017, 8, 2073. [Google Scholar] [CrossRef] [PubMed] [Green Version]
- Naeem, M.; Munir, M.; Li, H.J.; Raza, M.A.; Song, C.; Wu, X.L.; Irshad, G.; Khalid, M.H.B.; Yang, W.Y.; Chang, X.L. Transcriptional responses of Fusarium graminearum interacted with soybean to cause root rot. J. Fungi 2021, 7, 422. [Google Scholar] [CrossRef] [PubMed]
- Naseri, B. Epidemics of Rhizoctonia root rot in association with biological and physicochemical properties of field soil in bean crops. J. Phytopathol. 2013, 161, 397–404. [Google Scholar] [CrossRef]
- Naseri, B. Bean production and Fusarium root rot in diverse soil environments in Iran. J. Soil Sci. Plant Nutr. 2014, 14, 177–188. [Google Scholar] [CrossRef] [Green Version]
- John, R.P.; Tyagi, R.D.; Prévost, D.; Brar, S.K.; Pouleur, S.; Surampalli, R.Y. Mycoparasitic Trichoderma viride as a biocontrol agent against Fusarium oxysporum f. sp. adzuki and Pythium arrhenomanes and as a growth promoter of soybean. Crop Prot. 2010, 29, 1452–1459. [Google Scholar]
- Berendsen, R.L.; Pieterse, C.M.J.; Bakker, P.A.H.M. The rhizosphere microbiome and plant health. Trends Plant Sci. 2012, 17, 478–486. [Google Scholar] [CrossRef]
- Wang, L.Y.; Xie, Y.S.; Cui, Y.Y.; Xu, J.; He, W.; Chen, H.G.; Guo, J.H. Conjunctively screening of biocontrol agents (BCAs) against fusarium root rot and fusarium head blight caused by Fusarium graminearum. Microbiol. Res. 2015, 177, 34–42. [Google Scholar] [CrossRef]
- Benitez, T.; Rincon, A.M.; Limon, M.C.; Codon, A.C. Biocontrol mechanisms of Trichoderma strains. Int. Microbiol. 2004, 7, 249–260. [Google Scholar]
- Wending, R. Trichodema lignorum as a parasite of other soil fungi. Phytopathology 1932, 22, 837–845. [Google Scholar]
- Harman, G.E.; Howell, C.R.; Viterbo, A.; Chet, I.; Lorito, M. Trichoderma species-opportunistic, avirulent plant symbionts. Nat. Rev. Microbiol. 2004, 2, 43–56. [Google Scholar] [CrossRef]
- Izquierdo-García, L.F.; González-Almario, A.; Cotes, A.M.; Moreno-Velandia, C.A. Trichoderma virens Gl006 and Bacillus velezensis Bs006: A compatible interaction controlling Fusarium wilt of cape gooseberry. Sci. Rep. 2020, 10, 6857. [Google Scholar] [CrossRef] [PubMed] [Green Version]
- Lynch, J.M.; Lumsden, R.D.; Atkey, P.T.; Ousley, M.A. Prospects for control of Pythium damping-off of lettuce with Trichoderma, Gliocladium, and Enterobacter spp. Biol. Fertil. Soils 1991, 12, 95–99. [Google Scholar] [CrossRef]
- Anees, M.; Tronsmo, A.; Edel-Hermann, V.; Hjeljord, L.G.; Héraud, C.; Steinberg, C. Characterization of field isolates of Trichoderma antagonistic against Rhizoctonia solani. Fungal. Biol. 2010, 114, 691–701. [Google Scholar] [CrossRef] [PubMed]
- Lahlali, R.; Hijri, M. Screening, identification and evaluation of potential biocontrolfungal endophytes against Rhizoctonia solani AG3 on potato plants. FEMS Microbiol. Lett. 2010, 311, 152–159. [Google Scholar] [CrossRef]
- Li, J.Y.; Lu, C.G.; Liu, T.; Liu, W.C.; Su, H.J. Trichoderma brevicompactum BF06, a novel strain with potential for biocontrol of soil-borne diseases and promotion of plant growth of cucumber. Chin. J. Biol. Control 2018, 34, 449–460. [Google Scholar]
- Zhang, Y.; Tian, C.; Xiao, J.L.; Wei, L.; Tian, Y.; Liang, Z.H. Soil inoculation of Trichoderma asperellum M45a regulates rhizosphere microbes and triggers watermelon resistance to Fusarium wilt. AMB Express 2020, 10, 189. [Google Scholar] [CrossRef]
- Cotxarrera, L.; Trillas-Gay, M.I.; Steinberg, C.; Alabouvette, C. Use of sewage sludge compost and Trichoderma asperellum isolates to suppress Fusarium wilt of tomato. Soil Biol. Biochem. 2002, 34, 467–476. [Google Scholar] [CrossRef]
- Hermosa, R.; Viterbo, A.; Chet, I.; Monte, E. Plant-beneficial effects of Trichoderma and of its genes. Microbiology 2012, 158, 17–25. [Google Scholar] [CrossRef] [Green Version]
- Abdelrahman, M.; Abdel-Motaal, F.; El-Sayed, M.; Jogaiah, S.; Shigyo, M.; Ito, S.I.; Tran, L.S.P. Dissection of Trichoderma longibrachiatum-induced defense in onion (Allium cepa L.) against Fusarium oxysporum f. sp. cepa by target metabolite profiling. Plant Sci. 2016, 246, 128–138. [Google Scholar]
- Alfiky, A.; Weisskopf, L. Deciphering Trichoderma-Plant-Pathogen Interactions for Better Development of Biocontrol Applications. J. Fungi 2021, 7, 61. [Google Scholar] [CrossRef]
- Rolfe, S.A.; Griffiths, J.; Ton, J. Crying out for help with root exudates: Adaptive mechanisms by which stressed plants assemble health-promoting soil microbiomes. Curr. Opin. Microbiol. 2019, 49, 73–82. [Google Scholar] [CrossRef] [PubMed]
- Chen, J.; Zhou, L.; Din, I.U.; Arafat, Y.; Li, Q.; Wang, J. Antagonistic activity of Trichoderma spp. against Fusarium oxysporum in rhizosphere of Radix pseudostellariae triggers the expression of host defense genes and improves its growth under long-term monoculture system. Front. Microbiol. 2021, 12, 579920. [Google Scholar] [CrossRef] [PubMed]
- Yang, F.; Wang, X.C.; Liao, D.P.; Lu, F.Z.; Gao, R.C.; Liu, W.G.; Yong, T.W.; Wu, X.L.; Du, J.B.; Liu, J.; et al. Yield response to different planting geometries in maize-soybean relay strip intercropping systems. Agron. J. 2015, 107, 296–304. [Google Scholar] [CrossRef]
- Chen, P.; Du, Q.; Liu, X.N.; Zhou, L.; Hussain, S.; Lei, L.; Song, C.; Wang, X.C.; Liu, W.G.; Yang, F.; et al. Effects of reduced nitrogen inputs on crop yield and nitrogen use efficiency in a long-term maize-soybean relay strip intercropping system. PLoS ONE 2017, 12, e0184503. [Google Scholar] [CrossRef] [PubMed] [Green Version]
- Song, C.; Wang, Q.L.; Zhang, X.F.; Sarpong, C.K.; Wang, W.J.; Yong, T.W.; Wang, X.C.; Wang, Y.; Yang, W.Y. Crop productivity and nutrients recovery in maize-soybean additive relay intercropping systems under subtropical regions in Southwest China. Int. J. Plant Prod. 2020, 14, 373–387. [Google Scholar] [CrossRef]
- Song, C.; Sarpong, C.K.; Zhang, X.F.; Wang, W.J.; Wang, L.F.; Gan, Y.F.; Yong, T.W.; Chang, X.L.; Wang, Y.; Yang, W.Y. Mycorrhizosphere bacteria and plant-plant interactions facilitate maize Pacquisition in an intercropping system. J. Clean. Prod. 2021, 314, 127993. [Google Scholar] [CrossRef]
- Su, B.Y.; Liu, X.; Cui, L.; Xiang, B.; Yang, W.Y. Suppression of weeds and increases in food production in higher crop diversity planting arrangements: A case study of relay intercropping. Crop. Sci. 2018, 58, 1729–1739. [Google Scholar] [CrossRef]
- Liu, X.; Rahman, T.; Song, C.; Su, B.; Yang, F.; Yong, T.W.; Wu, Y.S.; Zhang, C.Y.; Yang, W.Y. Changes in light environment, morphology, growth and yield of soybean in maize-soybean intercropping systems. Field Crop. Res. 2017, 200, 38–46. [Google Scholar] [CrossRef]
- Du, J.B.; Han, T.F.; Gai, J.Y.; Yong, T.W.; Sun, X.; Wang, X.C. Maize-soybean strip intercropping: Achieved a balance between high productivity and sustainability. J. Integr. Agric. 2018, 17, 747–754. [Google Scholar] [CrossRef] [Green Version]
- Ren, L.X.; Su, S.M.; Yang, X.M.; Xu, Y.C.; Huang, Q.W.; Shen, Q. Intercropping with aerobic rice suppressed Fusarium wilt in watermelon. Soil Biol. Biochem. 2008, 40, 834–844. [Google Scholar] [CrossRef]
- Zhou, X.G.; Yu, G.B.; Wu, F.Z. Effects of intercropping cucumber with onion or garlic on soil enzyme activities, microbial communities and cucumber yield. Eur. J. Soil Biol. 2011, 47, 279–287. [Google Scholar] [CrossRef]
- Hage-Ahmed, K.; Krammer, J.; Steinkellner, S. The intercropping partner affects arbuscular mycorrhizal fungi and Fusarium oxysporum f. sp. lycopersici interactions in tomato. Mycorrhiza 2013, 23, 543–550. [Google Scholar] [CrossRef] [PubMed] [Green Version]
- Beyer, M.; Klix, M.B.; Klink, H.; Verreet, J.A. Quantifying the effects of previous crop, tillage, cultivar and triazole fungicides on the deoxynivalenol content of wheat grain-a review. J. Plant Dis. Prot. 2006, 113, 241–246. [Google Scholar] [CrossRef]
- Liu, J.B.; Xu, Y.L.; Wei, W. Comparing different methods for isolating Fusarium from soybean rhizosphere soil. Soybean Sci. 2008, 1, 106–112. [Google Scholar]
- Jie, W.G.; Bai, L.; Yu, W.J.; Cai, B.Y. Analysis of interspecific relationships between Funneliformis mosseae and Fusarium oxysporum in the continuous cropping of soybean rhizosphere soil during the branching period. Biocontrol. Sci. Technol. 2015, 25, 1036–1051. [Google Scholar] [CrossRef]
- Setälä, H.; McLean, M.A. Decomposition rate of organic substrates in relation to the species diversity of soil saprophytic fungi. Oecologia 2004, 139, 98–107. [Google Scholar] [CrossRef]
- Pérez-Brandán, C.; Huidobro, J.; Grümberg, B.; Scandiani, M.M.; Luque, A.G.; Meriles, J.M.; Vargas-Gil, S. Soybean fungal soil-borne diseases: A parameter for measuring the effect of agricultural intensification on soil health. Can. J. Microbiol. 2014, 60, 73–84. [Google Scholar] [CrossRef]
- Lian, T.X.; Mu, Y.H.; Ma, Q.B.; Cheng, Y.B.; Gao, R.; Cai, Z.D.; Jiang, B.; Nian, H. Use of sugarcane–soybean intercropping in acid soil impacts the structure of the soil fungal community. Sci. Rep. 2018, 8, 14488. [Google Scholar] [CrossRef] [Green Version]
- Djonovic, S.; Vargas, W.A.; Kolomiets, M.V.; Horndeski, M.; Wiest, A.; Kenerley, C.M. A proteinaceous elicitor Sm1 from the beneficial fungus Trichoderma virens is required for induced systemic resistance in maize. Plant Physiol. 2007, 145, 875–889. [Google Scholar] [CrossRef] [Green Version]
- Jogaiah, S.; Abdelrahman, M.; Tran, L.S.P.; Ito, S.I. Different mechanisms of Trichoderma virens-mediated resistance in tomato against Fusarium wilt involve the jasmonic and salicylic acide pathways. Mol. Plant Pathol. 2018, 19, 870–882. [Google Scholar] [CrossRef] [Green Version]
- Sivan, A.; Chet, I. Degradation of fungal cell walls by lytic enzymes from Trichoderma harzianum. J. Gen. Microbiol. 1989, 135, 675–682. [Google Scholar]
- Elad, Y.; Chet, I.; Henis, Y. Biological control of Rhizoctonia solani in strawberry fields by Trichoderma harzianum. Plant Soil 1981, 60, 245–254. [Google Scholar] [CrossRef]
- O’Donnell, K.; Kistler, H.C.; Cigelnik, E.; Ploetz, R.C. Multiple evolutionary origins of the fungus causing Panama disease of banana: Concordant evidence from nuclear and mitochondrial gene genealogies. Proc. Natl. Acad. Sci. USA 1998, 95, 2044–2049. [Google Scholar] [CrossRef] [PubMed] [Green Version]
- O’Donnell, K.; Sutton, D.A.; Rinaldi, M.G.; Sarver, B.A.J.; Balajee, S.A.; Schroers, H.-J.; Summerbell, R.C.; Robert, V.A.R.G.; Crous, P.W.; Zhang, N.; et al. Internet-accessible DNA sequence database for identifying Fusarium from human and animal infections. J. Clin. Microbiol. 2010, 48, 3708–3718. [Google Scholar] [CrossRef] [PubMed] [Green Version]
- O’Donnell, K.; Rooney, A.P.; Proctor, R.H.; Brown, D.W.; McCormick, S.P.; Ward, T.J.; Frandsen, R.J.N.; Lysøe, E.; Rehner, S.A.; Aoki, T.; et al. Phylogenetic analyses of RPB1 and RPB2 support a middle Cretaceous origin for a clade comprising all agriculturally and medically important fusaria. Fungal. Genet. Biol. 2013, 52, 20–31. [Google Scholar] [CrossRef] [PubMed]
- White, T.J.; Bruns, T.D.; Lee, S.B.; Taylor, J.W. Amplification sand direct sequencing of fungal ribosomal RNA genes for phylogenetics. PCR Protoc. 1990, 18, 315–322. [Google Scholar]
- Jaklitsch, W.M.; Komon, M.; Kubicek, C.P.; Druzhinina, I.S. Hypocrea voglmayrii sp. nov. from the Austrian Alps represents a new phylogenetic clade in Hypocrea/Trichoderma. Mycologia 2005, 97, 1365–1378. [Google Scholar] [CrossRef]
- Liu, Y.J.; Whelen, S.; Hall, B.D. Phylogenetic relationships among ascomycetes: Evidence from an RNA polymerse II subunit. Mol. Biol. Evol. 1999, 16, 1799–1808. [Google Scholar] [CrossRef]

| Cropping Patterns | Soil Samples | Sample Code | Trichoderma Richness (cfu·g−1) | Fusarium Richness (cfu·g−1) |
|---|---|---|---|---|
| Intercropping | Diseased rhizosphere soil | IDR | 2560.98 ± 2414.51 ab | 1046.51 ± 164.44 a |
| Healthy rhizosphere soil | IHR | 4404.76 ± 168.36 a | 329.67 ± 186.49 b | |
| Monoculture | Diseased rhizosphere soil | MDR | 523.26 ± 82.22 b | 391.62 ± 12.88 b |
| Healthy rhizosphere soil | MHR | 523.26 ± 82.22 b | 458.09 ± 151.62 b |
Publisher’s Note: MDPI stays neutral with regard to jurisdictional claims in published maps and institutional affiliations. |
© 2022 by the authors. Licensee MDPI, Basel, Switzerland. This article is an open access article distributed under the terms and conditions of the Creative Commons Attribution (CC BY) license (https://creativecommons.org/licenses/by/4.0/).
Share and Cite
Xu, H.; Yan, L.; Zhang, M.; Chang, X.; Zhu, D.; Wei, D.; Naeem, M.; Song, C.; Wu, X.; Liu, T.; et al. Changes in the Density and Composition of Rhizosphere Pathogenic Fusarium and Beneficial Trichoderma Contributing to Reduced Root Rot of Intercropped Soybean. Pathogens 2022, 11, 478. https://doi.org/10.3390/pathogens11040478
Xu H, Yan L, Zhang M, Chang X, Zhu D, Wei D, Naeem M, Song C, Wu X, Liu T, et al. Changes in the Density and Composition of Rhizosphere Pathogenic Fusarium and Beneficial Trichoderma Contributing to Reduced Root Rot of Intercropped Soybean. Pathogens. 2022; 11(4):478. https://doi.org/10.3390/pathogens11040478
Chicago/Turabian StyleXu, Huiting, Li Yan, Mingdi Zhang, Xiaoli Chang, Dan Zhu, Dengqin Wei, Muhammd Naeem, Chun Song, Xiaoling Wu, Taiguo Liu, and et al. 2022. "Changes in the Density and Composition of Rhizosphere Pathogenic Fusarium and Beneficial Trichoderma Contributing to Reduced Root Rot of Intercropped Soybean" Pathogens 11, no. 4: 478. https://doi.org/10.3390/pathogens11040478
APA StyleXu, H., Yan, L., Zhang, M., Chang, X., Zhu, D., Wei, D., Naeem, M., Song, C., Wu, X., Liu, T., Chen, W., & Yang, W. (2022). Changes in the Density and Composition of Rhizosphere Pathogenic Fusarium and Beneficial Trichoderma Contributing to Reduced Root Rot of Intercropped Soybean. Pathogens, 11(4), 478. https://doi.org/10.3390/pathogens11040478

